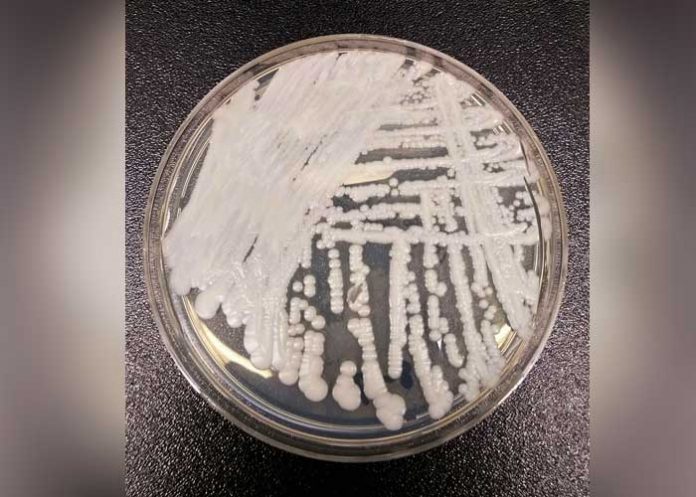
bac_nuQLKnn

Un hongo resistente a fármacos está apareciendo como una nueva amenaza en hospitales de Estados Unidos, principalmente en Nueva York y Nueva Jersey.
Tras ser identificado por primera vez en Japón en 2009, el hongo se ha esparcido a más de una decena de países. El más antiguo de los casos reportados en Estados Unidos data de 2013, pero la mayoría fueron reportados en el último año.
El hongo, llamado Candida auris, es una forma dañina de levadura. Los científicos dicen que puede ser difícil de identificarlo con pruebas de laboratorio estándar. Funcionarios federales de salud hicieron sonar las alarmas en 2016 debido a que dos de tres tipos de fármacos de uso común contra hongos tuvieron poco efecto.
"Esta actuando como una superbacteria", dijo la doctora Paige Armstrong de los Centros para el Control y la Prevención de Enfermedades (CDC por sus iniciales en inglés).
Las personas más vulnerables son pacientes frágiles hospitalizados, en particular los recién nacidos y los ancianos. El hongo tiene a ser diagnosticado en pacientes después de que han estado hospitalizados varias semanas. El hongo puede infectar heridas, oídos y el torrente sanguíneo.
Un estudio presentado esta semana en una conferencia de los CDC detalló el viaje de investigadores a Sudamérica para ayudar a indagar una epidemia en tres ciudades de Colombia. Encontraron el hongo sobre superficies en habitaciones de hospital y sobre la piel de enfermeras y pacientes, incluso después de que los pacientes fueron tratados con medicamentos antifúngicos.
El martes, funcionarios estatales de salud proporcionaron detalles nuevos sobre los 44 casos registrados en Nueva York. Aparte de un caso en Rochester, todos ocurrieron en la ciudad de Nueva York, en 15 hospitales y en el consultorio de un médico. Ningún sitio tenía más de seis casos.
Diecisiete pacientes de Nueva York murieron, pero funcionarios estatales señalaron que todas las personas infectadas tenían otras enfermedades y que el hongo no fue necesariamente la causa de fallecimiento.
Nueva Jersey ha tenido 15 casos, Illinois 4, y ha habido un caso en Indiana, Maryland y Massachusetts, según los CDC.